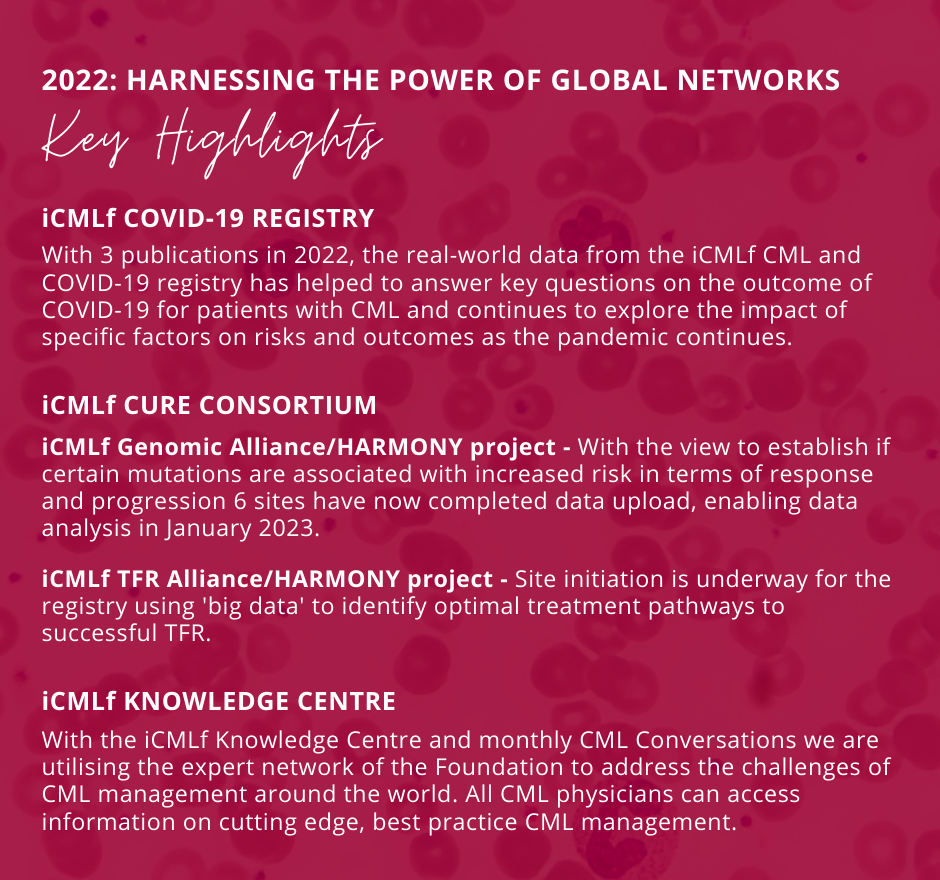
Merry Christmas 940 1100 px

As the year draws to a close we would like to express our appreciation for your continued interest, support and commitment to our work. 2022 has been a great success for the Foundation, with advancements in our CML research and expanding our ongoing commitment to the global CML community. Despite finding our way into a ‘new norm’ after the peak of the pandemic, together we rose to the challenges for one shared mission:
Improving the outcomes for people with CML globally
We look forward to 2023 and all it has to offer! We are excited to see the first results from the iCMLf Genomics Alliance and to build on our Knowledge Centre by connecting with CML physicians though regional discussion groups and of course, to Climb for a Cure in November. With 19 climbers already registered, we couldn’t be more excited to climb to Annapurna Base Camp in Nepal. Though it will be challenging, it’s a challenge we will conquer together to raise vital funds to get closer to a CML cure.
We wish a Merry Christmas to those celebrating and happy holidays to all. May the next year be prosperous, full of good health and success.










